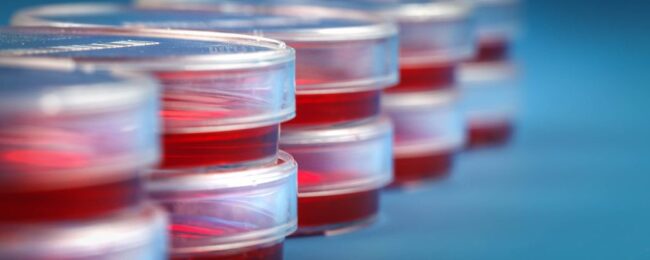

BLOOD CULTURE
What Is A Blood Culture Test?A blood culture test checks the blood for bacteria and other microorganisms that might have gotten into it. When these pathogens are found in the blood, it can be a sign of a blood infection called bacteremia. If your blood culture test returns positive, it means bacteria are in your…